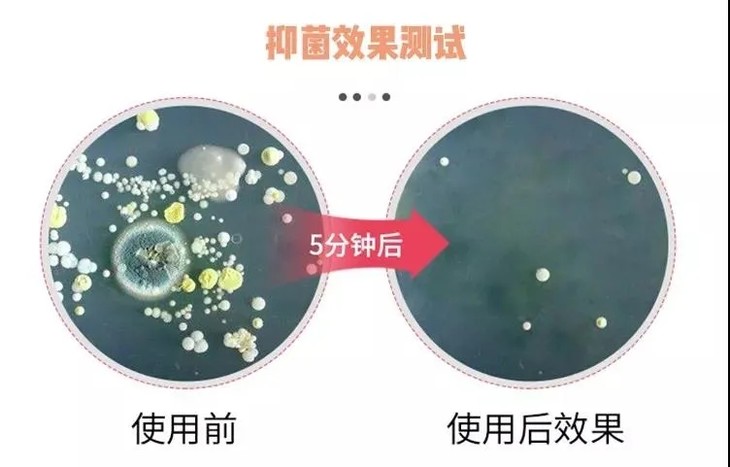

【品名】笙木之源内衣清洗液茶树精油款
原价:59元
活动价:49元
直播最低价:49元
成本:34元
活动毛利:30.61%
直播毛利:30.61%
规格:买一送一,共2瓶,每瓶500g
保质期:3年
发货地:杭州
物流:韵达,新疆西藏不发货,发货时效正常48小时内。
产品短链接:https://j.youzan.com/QEYdLs
【产品卖点】
1.笙木之源,新晋品质国货,曾与日本花王等大牌共同合作。旗下的笙木之源内衣洗液X猫累计销售65w+,受到众多消费者实力认证。
2.湖南卫视《我是你的蓝朋友》综艺嘉宾维嘉倾情推荐,明星赵奕欢直播力荐,小红书种草达人好评满满!
3.采用世界级提炼技术,国家质检中心认证,澳洲进口茶树精油+洋甘菊提取物,双重抑菌,有效抑菌率高达99%!
4.添加高活性蛋白酶,深入瓦解污渍。一瓶多用,不仅能清洗内衣裤,还适用于婴幼儿衣物、普通衣物、化妆工具等清洁杀菌。
5.添加护手霜同款成分椰子油,洗液整体PH值呈弱酸性,温和亲肤,不会产生刺激。不含苯、荧光剂、磷、氯漂等有害成分,孕妇也可使用~
6.与国际一线香氛品牌“瑞士奇华顿”合作,推出定制清新高级白茶香气,持久留香,清香扑鼻。
7.一瓶500g大容量,满足全家人的日常所需。秋千盖瓶口设计,既卫生又好控制用量。


-----------------分割线-----------------
!!图片灵活运用!!
【朋友圈】
墙裂安利这款笙木之源内衣清洁液
从粉丝口中得来的口碑
一款“大姨妈”都怕的清洁液
高达99%的抑菌率,内衣内裤洗干净了
妇科疾病都能轻松saybye~
原价59元1瓶
粉丝专享 买一送一!只要49元
购买链接:https://j.youzan.com/QEYdLs



【社群--要分段插图!!】
给大家墙裂安利这款内衣清洁液
口碑一直很不错,有和花王合作过,产品质量值得信赖
不仅抑菌能力超强,清洁去污能力也相当能打!
添加了专为解决顽固污渍的高活性蛋白酶
它不会遇水即化,能打入内部瓦解污渍
以后再也不用为清洗内衣内裤而头疼尴尬了
为了健康,大家都要用起来呀~
原价59元1瓶
现在社群福利 买一送一!只要49元
购买链接:https://j.youzan.com/QEYdLs
还能用来洗化妆刷、粉扑、婴儿衣物
一瓶多用,超省心

【用户晒图】





【其他可用素材】
--实拍视频
--荧光剂测试视频
--湖南卫视推荐视频
--赵奕欢直播推荐
--图片素材





--资质安全




【产品拓展素材】
--关于内衣健康
内衣裤是女人重要部位的“保护伞”,我们每天穿着十几二十小时,如果不注意它的清洁和除菌,很容易就患上不明不白的“妇科病”。
如果私处的白带异常多,可能就是内裤上有金黄色葡萄球菌(女性内裤上遗留的常客,妇科病罪魁祸首之一)
--为什么要用专门的清洗液洗内衣内裤?
很多人是用洗衣液、洗衣粉或是肥皂来洗内裤的,但普通的碱性清洗剂,是并不能有效杀死细菌的,而且很容易破坏私处的酸碱平衡。
北医妇科的李烨主任公开建议:“内裤的干净程度对于女性的身体健康是非常重要的,手洗很有必要,但要用内衣专用的清洗液才有用!”